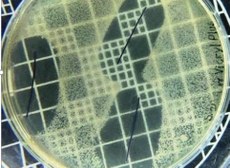
Na imagem, é possível verificar inibição de 20 mm utilizando os fios de sutura contendo agente antimicrobiano, frente à bactéria S.aureus, encontrada na pele e nas fossas nasais. Crédito: Fábio Sampaio

Notícias
Pesquisadores da UFPB desenvolvem fio de sutura antimicrobiano
Pesquisadores da Universidade Federal da Paraíba (UFPB) desenvolveram um fio de sutura revestido de óleo essencial antimicrobiano. Ao ser aplicado em ferida cirúrgica, o fio libera substância de modo lento e constante para evitar infecção. O óleo essencial antimicrobiano vem de planta cultivada em uma área de horto medicinal no campus I da UFPB, em João Pessoa.
Comparado ao fio de sutura comercial, que contém triclosan, um agente bacteriostático comumente usado como antisséptico e conservante em cosméticos, o fio revestido com óleo essencial da UFPB apresentou ação antimicrobiana melhor ou semelhante.
A inovação foi desenvolvida pelo professor Fábio Sampaio, chefe do setor de pesquisa e inovação tecnológica do Hospital Universitário Lauro Wanderley, administrado pela UFPB no campus I, em João Pessoa; pela professora do Departamento de Odontologia Restauradora, Isabela Farias; e pelas pesquisadoras Lília van der Linden e Karoline Silveira.
Os testes foram realizados em 2017 e 2018, no Laboratório de Biologia Bucal (Labial) e Núcleo de Estudos e Pesquisas Interdisciplinares em Biomateriais (Nepibio) da UFPB, também no campus I, em João Pessoa.
Segundo Fábio Sampaio, no mercado, existe apenas um fio de sutura cirúrgico com revestimento antibacteriano. Esse fio de sutura demonstrou, em alguns estudos, que não houve diferenças na diminuição de incidência de infecção do local cirúrgico quando comparado a fios sem agente antimicrobiano.
Além disso, a produção desse fio de sutura cirúrgico presente no mercado tem alto custo financeiro e o agente antimicrobiano contido nele é fisiologicamente prejudicial à saúde reprodutiva em humanos e outros animais.
“Ele também resulta em produto tóxico secundário, como o dióxido, considerado uma séria ameaça ao meio ambiente, e promove resistência a múltiplos fármacos. Por isso, existia essa necessidade de criar um produto inovador que possa substituí-lo com eficácia, rentabilidade e segurança”, afirma o professor da UFPB.
Para o chefe do setor de pesquisa e inovação tecnológica do Hospital Universitário Lauro Wanderley da UFPB, pacientes submetidos a procedimentos cirúrgicos orais poderão ser beneficiados pela patente.
“O potencial da invenção é evidente, mas ainda não fizemos um estudo da versão mais aprimorada do produto. Estamos em uma versão alfa, um produto ainda em desenvolvimento. Nossa expectativa é que, em dois anos, poderemos mensurar o impacto da invenção no mercado”.
As pesquisas de bancada estão sendo finalizadas. Em seguida, será realizado o estudo in vivo, em animais, coordenado por Fábio Sampaio, pela professora Joelma Souza e pela pesquisadora Lília van der Linden. “Sendo satisfatórios os resultados, seguiremos com uma futura pesquisa em humanos”, adianta o docente.
A pesquisa é financiada pelo Conselho Nacional de Desenvolvimento Científico e Tecnológico (CNPQ) e pela UFPB e conta com o apoio do engenheiro agrônomo da federal paraibana, Fernando Viana, que garante a qualidade do material vegetal impregnado no fio de sutura. Interessados no estudo devem entrar em contato pelo e-mail fcsampa@gmail.com.
* * *
Reportagem e Edição: Pedro Paz
Ascom/UFPB